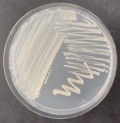
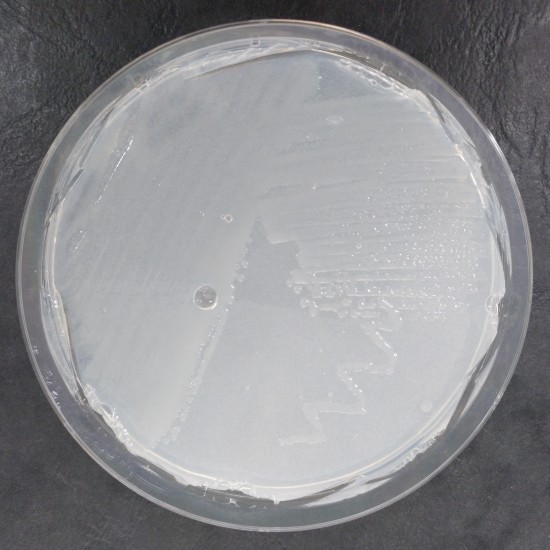
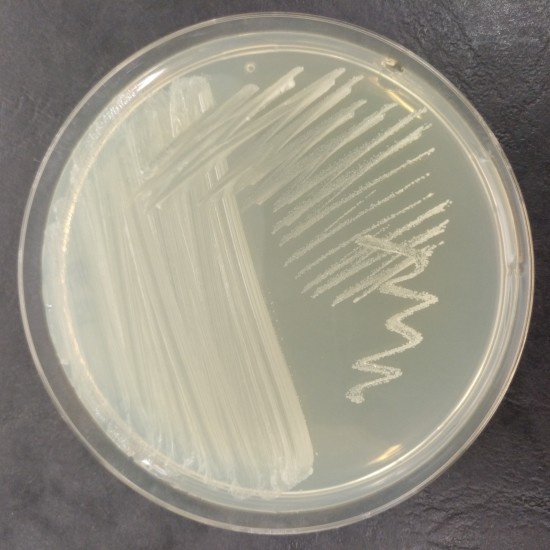
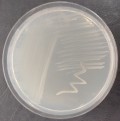

CECT 8629
BACTERIA
Type strain
| Name | Pseudorhizobium pelagicum Kimes et al. 2015 | ||||
| Synonym(s) | Rhizobium marinum subsp. pelagicum (Kimes et al. 2017) Hördt et al. 2020 | ||||
| Strain designation | R1-200B4 | ||||
| Other collections | LMG 28314 | ||||
| Access in situ (sampling data) | Source: Pelagic zone of the Mediterranean Sea off the coast of Alicante Country of access: Spain Date of access: Before 01-02-2013 | ||||
| Isolation data | Isolated by: Kimes, N. Date of isolation: 01-02-2013 | ||||
| History | CECT, 2014 < E. Velázquez, Univ. Salamanca, Spain < N. Kimes, Univ. Miguel Hernández, Spain | ||||
| Growth conditions | Liquid media: 209 Solid media: 344 Growth temperature (in °C): 30 Incubation time: 72h Atmospheric needs: aerobic Cultivation conditions for CECT strains | ||||
| Restrictions | Risk group: 1 Restrictions on ABS imposed by the country of origin may apply CECT MTA | ||||
| Genetic data | G+C mol%: 62.8 mol% 16S rRNA sequence: NZ_JOKJ00000000 Complete genome sequence: GCA_000722615.1 | ||||
| Delivery |
| ||||
| La CECT sigue estándares de calidad para garantizar la viabilidad, pureza y autenticidad de las cepas que conserva. La información mostrada en esta ficha procede de diversas fuentes. Algunas de las propiedades no han sido necesariamente contrastadas por la CECT | |||||